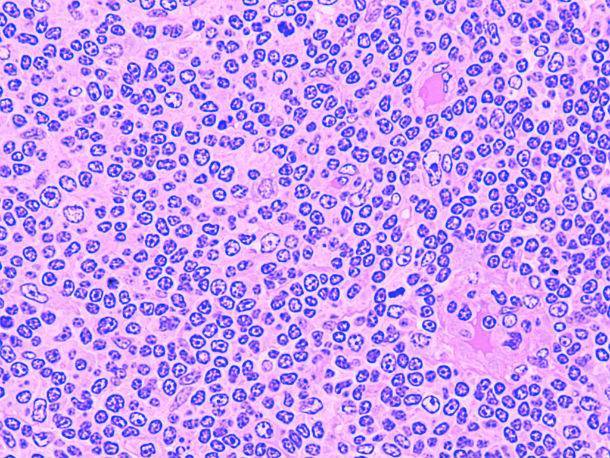

Лимфатические сосуды
Лимфатическая система тесно связана с системой крови и представляет собой дополнительный способ, с помощью которого лимфатическая жидкость может течь из тканей организма обратно в кровоток. Лимфатические сосуды можно классифицировать в лимфатические капилляры, пред-коллекторы, лимфатические коллекторы и лимфатические сундуки. Лимфатические капилляры представляют собой начало лимфатической системы дренажа и происходят в непосредственной близости от кровеносных капилляров. Лимфатические капилляры напоминают кровеносные капилляры, но имеют более нерегулярную структуру клеток и более проницаемы, чем кровеносные капилляры. Из-за своей структуры лимфатические капилляры способны поглощать более крупные частицы из тканей, такие как белки, клетки, бактерии и другие крупные вещества, которые не могут быть поглощены капиллярами крови. Эти частицы вместе с водой затем проходят через сложную сеть сборщиков и более крупных коллекторов и стволов лимфы обратно в кровообращение через венозные углы.На обратном пути к крови лимфатическая жидкость перемещается через последовательное количество лимфатических узлов, которые отфильтровывают примеси из лимфы.
Реакция на инфекции: кровеносная и лимфатическая системы
Кровеносная и лимфатическая системы играют важную роль в защите организма от инфекций. Обе системы работают совместно, предоставляя иммунные механизмы для борьбы с патогенами и поддержания здоровья.
Кровеносная система состоит из сердца, кровеносных сосудов и крови. Кровь переносит кислород и питательные вещества к клеткам организма, а также удаляет отходы и токсины. Кровь также содержит клетки иммунной системы, такие как лейкоциты, которые играют важную роль в противостоянии инфекциям.
В случае инфекции, кровь может становиться особенно активной. Лейкоциты могут удалять инфекционные агенты, антитела начинают атаковать возбудителей болезни, и система свертывания крови включается для предотвращения распространения инфекции в теле.
Лимфатическая система состоит из лимфатических сосудов, лимфатических узлов и лимфы. Лимфатическая система играет роль в отводе жидкости из тканей и возвращении ее в кровеносную систему. Она также является основным компонентом иммунной системы, так как в ней происходит обнаружение и борьба с инфекционными агентами.
В результате инфекции лимфатическая система также становится активной. Лимфатические узлы становятся воспаленными и увеличенными, что указывает на присутствие инфекции. Внутри лимфатических узлов иммунные клетки – лимфоциты – противостоят инфекционным агентам.
Обе системы работают в тесном взаимодействии друг с другом, чтобы обнаруживать, бороться и устранять инфекции. Они обмениваются информацией и клетками, чтобы организм мог эффективно реагировать на инфекцию.
- Кровь переносит иммунные клетки по всему телу, чтобы искать и уничтожать инфекционные агенты.
- Лимфатическая система собирает и фильтрует лимфу, чтобы обнаружить и бороться с инфекционными агентами.
- Лимфатическая система также играет важную роль в адаптивном иммунитете, производя антитела и запоминая инфекции для будущей защиты.
Итак, кровеносная и лимфатическая системы вместе обеспечивают реакцию на инфекции и защиту организма от патогенов. Понимание их функций и взаимодействия помогает нам лучше понять, как работает наш иммунитет и как мы можем его поддерживать.
Состав лимфы
В состав лимфы входят: клеточные элементы, белки, липиды, низкомолекулярные органические соединения (аминокислоты, глюкоза, глицерин), электролиты. Клеточный состав лимфы представлен в основном лимфоцитами. В лимфе грудного протока их число достигает 8*109/л.Эритроциты в лимфе в норме встречаются в ограниченном количестве, их число значительно возрастает при травмах тканей, тромбоциты в норме не определяются. Макрофаги и моноциты встречаются редко. Гранулоциты могут проникать в лимфу из очагов инфекции.Ионный состав лимфы не отличается от ионного состава плазмы крови и интерстициальной жидкости. В то же время по содержанию и составу белков и липидов лимфа значительно отличается от плазмы крови. В лимфе человека содержание белков составляет в среднем 2—3% от объема.Концентрация белков в лимфе зависит от скорости ее образования: увеличение поступления жидкости в организм вызывает рост объема образующейся лимфы и уменьшает концентрацию белков в ней. В лимфе в небольшом количестве содержатся все факторы свертывания, антитела и различные ферменты, имеющиеся в плазме.
Холестерин и фосфолипиды находятся в лимфе в виде липопротеинов. Содержание свободных жиров, которые находятся в лимфе в виде хиломикронов, зависит от количества жиров, поступивших в лимфу из кишечника. Тотчас после приема пищи в лимфе грудного протока содержится большое количество липопротеинов и липидов, всосавшихся в желудочно-кишечном тракте. Между приемами пищи содержание липидов в грудном протоке минимально.
Лимфатическая система, её функции и строение
В организме животных кроме системы кровообращения есть система лимфообращения, возвращающая в кровь поступившую в ткани жидкость — лимфу. Лимфатическая система — составная часть сосудистой системы, обеспечивающая образование лимфы и лимфообращение.
Лимфатическая система начинается в тканях органов в виде разветвленной сети замкнутых лимфатических капилляров, которые не имеют клапанов, а их стенки обладают высокой проницаемостью и способностью всасывать коллоидные растворы и взвеси. Лимфатические капилляры переходят в лимфатические сосуды, снабженные клапанами. Благодаря этим клапанам, препятствующим обратному току лимфы, она течет только в направлении к венам. Лимфатические сосуды впадают в лимфатический грудной проток, через который течет лимфа от 3/4 организма. Грудной проток впадает в краниальную полую вену или яремную вену. Лимфа по лимфатическим сосудам поступает в правый лимфатический ствол, впадающий в краниальную полую вену.

Рис. Схема лимфатической системы
Функции лимфатической системы
Лимфатическая система выполняет несколько функций:
- защитную функцию обеспечивает лимфоидная ткань лимфатических узлов, вырабатывающая фагоцитарные клетки, лимфоциты и антитела. Перед входом в лимфатический узел лимфатический сосуд делится на мелкие ветви, которые переходят в синусы узла. От узла отходят также мелкие ветви, которые объединяются вновь в один сосуд;
- фильтрационная функция также связана с лимфатическими узлами, в которых механически задерживаются различные чужеродные вещества и бактерии;
- транспортная функция лимфатической системы заключается в том, что через эту систему в кровь поступает основное количество жира, который всасывается в желудочно-кишечном тракте;
- лимфатическая система выполняет также гомеостатическую функцию, поддерживая постоянство состава и объема интерстициальной жидкости;
- лимфатическая система выполняет дренажную функцию и удаляет избыток находящейся в органах тканевой (интерстициальной) жидкости.
Образование и циркуляция лимфы обеспечивают удаление избытка внеклеточной жидкости, который создается за счет того, что фильтрация превышает реабсорбцию жидкости в кровеносные капилляры. Такая дренажная функция лимфатической системы становится очевидной, если отток лимфы из какой-то области тела снижен или прекращен (например, при сдавливании конечностей одеждой, закупорке лимфатических сосудов при их травме, пересечении во время хирургической операции). В этих случаях дистальнее места сдавливания развивается местный отек ткани. Такой вид отека называют лимфатическим.
Возврат в кровеносное русло альбумина, профильтровавшегося в межклеточную жидкость из крови, особенно в органах, имеющих высокопроницаемые гистогематические барьеры (печень, желудочно-кишечный тракт). За сутки с лимфой в кровоток возвращается более 100 г белка. Без этого возврата потери белка кровью были бы невосполнимы.
Лимфа входит в систему, обеспечивающую гуморальные связи между органами и тканями. С ее участием осуществляется транспорт сигнальных молекул, биологически активных веществ, некоторых ферментов (гистаминаза, липаза).
В лимфатической системе завершаются процессы дифференцировки лимфоцитов, транспортируемых лимфой вместе с иммунными комплексами, выполняющими функции иммунной защиты организма.
Защитная функция лимфатической системы проявляется также в том, что в лимфоузлах отфильтровываются, захватываются и в ряде случаев обезвреживаются инородные частицы, бактерии, остатки разрушенных клеток, различные токсины, а также опухолевые клетки. С помощью лимфы удаляются из тканей эритроциты, вышедшие из кровеносных сосудов (при травмах, повреждениях сосудов, кровотечениях). Нередко накопление токсинов и инфекционных агентов в лимфатическом узле сопровождается его воспалением.
Лимфа участвует в транспорте в венозную кровь большого круга кровообращения хиломикронов, липопротеинов и жирорастворимых веществ, всасывающихся в кишечнике.
Кровь и лимфа
Кровь — внутренняя среда организма, образованная жидкой соединительной тканью. Состоит из плазмы и форменных элементов: клеток лейкоцитов и постклеточных структур (эритроцитов и тромбоцитов), которые представлены на рисунке 3. Циркулирует по системе сосудов под действием силы ритмически сокращающегося сердца и не сообщается непосредственно с другими тканями тела ввиду наличия гистогематических барьеров. В среднем, массовая доля крови к общей массе тела человека составляет 6,5-7 %. У позвоночных кровь имеет красный цвет (от бледно- до тёмно-красного), который ей придаёт гемоглобин, содержащийся в эритроцитах. У некоторых моллюсков и членистоногих кровь имеет голубой цвет за счёт наличия гемоцианина.
Рисунок 3 – Клетки крови
Плазма крови — жидкая часть крови, которая содержит воду и взвешенные в ней вещества — белки и другие соединения. Основными белками плазмы являются альбумины, глобулины и фибриноген. Около 85 % плазмы составляет вода. Неорганические вещества составляют около 2-3 %; это катионы (Na+, K+, Mg2+, Ca2+) и анионы (HCO3-, Cl-, PO43-, SO42-). Органические вещества (около 9 %) в составе крови подразделяются на азотсодержащие (белки, аминокислоты, мочевина, креатинин, аммиак, продукты обмена пуриновых и пиримидиновых нуклеотидов) и безазотистые (глюкоза, жирные кислоты, пируват, лактат, фосфолипиды, триацилглицеролы, холестерин). Также в плазме крови содержатся газы (кислород, углекислый газ) и биологически активные вещества (гормоны, витамины, ферменты, медиаторы).
Форменные элементы крови представлены эритроцитами, тромбоцитами и лейкоцитами:
Эритроциты (красные кровяные тельца) — самые многочисленные из форменных элементов. Зрелые эритроциты не содержат ядра и имеют форму двояковогнутых дисков. Циркулируют 120 дней и разрушаются в печени и селезёнке. В эритроцитах содержится железосодержащий белок — гемоглобин. Он обеспечивает главную функцию эритроцитов — транспорт газов, в первую очередь — кислорода. Именно гемоглобин придаёт крови красную окраску. В лёгких гемоглобин связывает кислород, превращаясь в оксигемоглобин, который имеет светло-красный цвет. В тканях оксигемоглобин высвобождает кислород, снова образуя гемоглобин, и кровь темнеет. Кроме кислорода, гемоглобин в форме карбогемоглобина переносит из тканей в лёгкие углекислый газ.
Тромбоциты (кровяные пластинки) представляют собой ограниченные клеточной мембраной фрагменты цитоплазмы гигантских клеток костного мозга (мегакариоцитов). Совместно с белками плазмы крови (например, фибриногеном) они обеспечивают свёртывание крови, вытекающей из повреждённого сосуда, приводя к остановке кровотечения и тем самым защищая организм откровопотери.
Лейкоциты (белые клетки крови) являются частью иммунной системы организма. Они способны к выходу за пределы кровяного русла в ткани. Главная функция лейкоцитов — защита от чужеродных тел и соединений. Они участвуют в иммунных реакциях, выделяя при этом Т-клетки, распознающие вирусы и всевозможные вредные вещества; В-клетки, вырабатывающие антитела,макрофаги, которые уничтожают эти вещества. В норме лейкоцитов в крови намного меньше, чем других форменных элементов.
Лимфа представляет собой прозрачную вязкую бесцветную жидкость, в которой нет эритроцитов, но много лимфоцитов. Выделяющаяся из мелких ран лимфа называется в просторечии сукровицей. Ток лимфы происходит снизу-вверх, от кончиков пальцев рук и ног до грудного лимфатического протока. Лимфатическая жидкость движется за счёт сокращения окружающих мышц и наличия в лимфатических протоках клапанов, предотвращающих обратный ход лимфы. Из капилляров лимфа поступает в лимфатические сосуды, а затем в протоки и стволы: слева в грудной проток (самый большой проток), левый яремный и левый подключичный стволы; справа в правый лимфатический проток, правый яремный и правый подключичный стволы. Протоки и стволы впадают в крупные вены шеи, а затем в верхнюю полую вену. На пути лимфатических сосудов расположены лимфатические узлы, выполняющие барьерную и иммунную роль.
Функция лимфы — возвращение белков, воды, солей, токсинов и метаболитов из тканей в кровь. В организме человека содержится 1-2 л лимфы. Лимфатическая система участвует в создании иммунитета, в защите от болезнетворных микробов и вирусов. По лимфатическим сосудам при обезвоживании и общем снижении защитных сил иммунитета возможно распространениепаразитов: простейших, бактерий, вирусов, грибков и др., что называют лимфогенным путем распространения инфекции, инвазии или метастазирования.
Роль кровеносной системы и лимфатической системы в организме
Кровеносная система состоит из сердца, кровеносных сосудов (артерий, вен и капилляров) и крови. Она играет центральную роль в организме, обеспечивая постоянное кровообращение и перенос кислорода, питательных веществ и других полезных веществ к клеткам органов и тканей. Кровь также удаляет углекислый газ и другие отходы обмена веществ из клеток и органов.
Лимфатическая система, в свою очередь, состоит из лимфатических сосудов, лимфатических узлов, лимфоидной ткани и лимфы. Она выполняет множество важных функций, таких как поддержание баланса воды и электролитов, защита организма от инфекций и обеспечение иммунной системы. Лимфатическая система отвечает за сбор и переработку лимфы – жидкости, содержащей в себе отработанные клетки, белки, бактерии и другие микроорганизмы, а также поглощение и передвижение лимфоцитов – клеток, ответственных за иммунный ответ организма.
В отличие от кровеносной системы, лимфатическая система не имеет центрального насоса и двигается благодаря сокращению мышц, дыханию и давлению, создаваемому органами и тканями на лимфатические сосуды. Также лимфатическая система отличается от кровеносной системы по составу транспортируемых веществ – лимфа содержит продукты обмена веществ, лимфоциты и другие вещества, отфильтрованные из крови.
Различия и сходства между кровеносной системой и лимфатической системой определяют их роли и значимость в организме. Хотя они выполняют разные функции, их работа тесно связана и взаимосвязана, обеспечивая нормальное функционирование организма и поддержание его внутренней среды.
Строение лимфатической системы
Лимфа
Лимфа – жидкость соломенного цвета, похожая на плазму крови, которая формируется в результате попадания веществ в жидкость, омывающую клетки. Она называется тканевой, или интерстициальной. жидкостью и образуется из плазмы крови. Лимфа связывает кровь и клетки, позволяя кислороду и питательным веществам поступать из крови в клетки, а продуктам распада и углекислому газу – обратно. Некоторое количество протеинов плазмы вытекает в прилежащие ткани и должно быть собрано обратно, чтобы не допустить образования отека. Около 10 процентов тканевой жидкости проникает в лимфатические капилляры, которые легко пропускают протеины плазмы, продукты распада, бактерии и вирусы. Остальные вещества, выходящие из клеток, подхватываются кровью капилляров и уносятся по венулам и венам обратно к сердцу.
Лимфатические сосуды
Лимфатические сосуды начинаются лимфатическими капиллярами, которые забирают из тканей избыточную тканевую жидкость. Они переходят в более крупные трубки и идут по те у параллельно с венами. Лимфатические сосуды схожи с венами, так как тоже имеют клапаны, предотвращающие ток лимфы в обратном направлении. Ток лимфы стимулируется скелетными мышцами, подобно току венозной крови.
Лимфатические узлы, ткани и протоки
Лимфатические сосуды проходят через лимфатические узлы, ткани и протоки, прежде чем соединяются с венами и подходят к сердцу, после чего весь процесс начинается заново.
Лимфоузлы
Известные также как железы они расположены в стратегических точках тела. Они образованы фиброзной тканью, содержащей разных клетки из белых клеток крови:
- Макрофаги – клетки, разрушающие нежелательные и вредные вещества (антигены), фильтруют лимфу, проходящую через лимфатические узлы.
- Лимфоциты – клетки, производящие защитные антитела против антигенов, собранных макрофагами.
Лимфа попадает в лимфатические узлы по афферентным сосудам, а выходит из них по эфферентным.
Лимфатическая ткань
Кроме лимфоузлов, лимфатическая ткань есть и в других зонах тела.
К ним относятся:
- Селезенка – расположена с левой стороны живота и образована лимфатической тканью. По строению она сходна с лимфоузлами, но больше по размеру, и участвует в образовании новых клеток и разрушении старых. Макрофаги селезенки удаляют старые, поврежденные эритроциты крови, расщепляя и перерабатывая их. Селезенка также служит резервуаром для крови. Кровь, хранящаяся в селезенке, может при необходимости направляться в другие части организма, например при потере крови/кровотечении.
- Зобная железа – расположена за грудиной в грудной клетке.
- Миндалины и аденоиды – находятся в горле (миндалины) и задней части носа (аденоиды). Они связаны с дыхательной системой и помогают бороться с опасными паразитами, которых мы вдыхаем.
- Аппендикс – находится в начале толстой кишки и защищает пищеварительную систему.
- Млечные сосуды – находятся в тонкой кишке, связаны с впитыванием жиров в пищеварительной системе. Пейеровы бляшки в нижней части тонкой кишки защищают от инфекции.
Лимфатические протоки
Лимфатические протоки забирают очищенную лимфу, выходящую из лимфоузлов, и направляют ее в вены.
Есть два лимфатических протока:
- Грудной проток – главный проток, тянущийся от поясничного позвонка до основания шеи. Он составляет около 40 см в длину и собирает лимфу из левой части головы, шеи и грудной клетки, левой руки, обеих ног, зон брюшной полости и таза и выпускает ее в левую подключичную вену.
- Правый лимфатический проток – составляющий всего 1 см в длину, расположен у основания шеи. Собирает лимфу и выпускает ее в правую подключичную вену.
После этого лимфа включается в кровообращение, и весь процесс повторяется заново.
Как сообщаются системы?
Составляющие крови отличаются от лимфатических. Кровь состоит из части жидкой плазмы, фракции белых кровяных телец, некоторого количества эритроцитов (окрашивающих кровь) и тромбоцитов (содержащих фибрин и отвечающих за свертывание крови). Фильтруемая через стенки сосудов лимфа, которая попадает в сердечно-сосудистую систему, больше похожа на молочно-белую или прозрачную жидкость. Любое повреждение на поверхности тела вызывает кровотечение. Это то, что вы можете увидеть. Но очень трудно обнаружить повреждения в лимфатической системе, даже если вы столкнулись с опуханием лимфатических узлов.
Кровь очищается в почках, именно там поглощаются ненужные организму продукты метаболизма, отходы и избыток жидкости удаляются. Как только это сделано, очищенные жидкости возвращаются в сердечно-сосудистую систему. Лимфатическая же система является самодостаточной. Лимфа очищается внутри лимфатических узлов, рассыпанных по всему телу, там удаляются отходы и убиваются некоторые из патогенных микроорганизмов.
https://youtube.com/watch?v=I71NP-g8RFs
Анатомия (строение) лимфатической системы
В структуру ЛСЧ входят:
- лимфа;
- лимфатические сосуды и капилляры;
- лимфоузлы (иммунные звенья, образования).
Кровеносная и лимфатическая система существенно отличаются друг от друга. В прозрачной жидкости нет эритроцитов, и белковых молекул содержится намного меньше, чем в крови. ЛСЧ не замкнутая. В ней отсутствует основной насос, т. е. сердце. Лимфа перемещается в ЛСЧ плавно и под минимальным давлением.
Строение лимфатической системы человека подскажет схема. Она также укажет особенности движения лимфы. Подробно составляющие важнейшей части организма описаны ниже.
Лимфа
Слово «лимфа» в переводе с латыни означает «чистая вода». Это неудивительно, ведь указанная жидкость очищает организм от вредных веществ. По своей структуре лимфа представляет собой соединительную ткань и обладает множеством лимфоцитов, практически не содержит тромбоцитов и эритроцитов.
В состав «чистой воды» входят продукты жизнедеятельности организма, в т. ч. большие молекулы белков. Чаще всего они являются вирусами, которые фильтрует лимфосистема. В прозрачной жидкости находятся разные гормоны, продуцируемые эндокринными железами.
Лимфа движется от периферии к центру, перемещаясь снизу вверх. Она проходит от небольших капилляров, которые постепенно вливаются в крупные сосуды. Движение идет через образования — лимфоузлы, выполняющие функцию фильтрации. Всего лимфосистема содержит около 500 таких анатомических структур.
Лимфатические сосуды и капилляры

Нажмите для увеличения
ЛСЧ внешне напоминает корни дерева. Это сближает ее с нервной и кровеносной системами. Лимфатические сосуды пронизывают практически все тело человека, исключая склеры, внутреннюю часть уха и некоторые др. сегменты.
Из тканей лимфа приходит в капилляры, которые соединяются в лимфососуды. Последние окружают все органы и часто ложатся в несколько слоев.
По сосудам лимфа проходит в регионарные звенья иммунитета, локализующиеся в паховой и локтевых областях, подмышечных впадинах, груди и пр. Из узлов выходят большие стволы, которые впадают в протоки, открывающие «чистой воде» дорогу в кровеносную систему.
Лимфатические узлы (иммунные звенья)
Лимфатический узел (ЛУ) — это, зачастую, округлое образование, имеющие серо-розовый цвет и размеры от 0,5 до 50 мм и больше. Иммунные звенья локализуются по ходу лимфатических и вблизи кровеносных сосудов. Каждое из образований служит своеобразным фильтром. Отвечают за очищение организма не только от микробов, но и от раковых клеток. Таким образом, оно является важнейшей частью здоровья человека.
В структуру узлов входят:
- соединительнотканная капсула;
- строма (структурная основа), в которой находятся макрофаги;
- корковое вещество, состоящее из поверхностной части и глубокой коры.
В основе иммунных звеньев находится лимфоидная ткань, в которой присутствуют лимфоциты, ретикулоциты и плазматические клетки. В образованиях развиваются важнейшие составляющие иммунитета – В-лимфоциты, участвующие в его становлении.
What is Lymph?
Lymph is a type of body fluid. The fluid is a part of the lymphatic system. Several lymph vessels or channels and lymph nodes constitute the lymphatic system in the body.
The system functions as a venous system and returns fluid from various tissues to the central circulation unit. Lymph is formed from interstitial fluid. The interstitial fluid surrounds blood and various cells to exchange substances.
Lymph can return protein and other interstitial fluid, which is excess in amount to the bloodstream. It is also responsible for transporting fat from the digestive system.
Any bacteria that enter the lymph channels and get transported to lymph nodes are destroyed. The lymphatic channels play a vital role in the circulation of the body. The composition of lymph is similar to blood plasma.
Lymph is also produced in the human digestive system. That is known as chyle and is rich in fats, triglycerides. The appearance of the substance is milky white because of the high lipid content.
The Lymph system plays a vital role in clinical pathology as a tool for screening in the analysis of the immune system. Lymph combined with other chemical biomarkers can determine the changes which occur in any disease.
Lymph plays a vital role as a growth medium. The use of lymph as a growth medium was first used in 1907 by a zoologist called Ross Granville Harrison.
The experiment was conducted on the growth of a frog nerve cell in a medium of lymph clotted. Later in 1913, the vaccinia virus was grown from Guinea pig‘s cornea in tissue culture of lymph medium.
Движение лимфы. Лимфатическая система. Движение лимфы
Кровеносная система – не единственная сосудистая система нашего организма. В большинстве органов в теле человека помимо кровеносных находятся лимфатические сосуды . Они содержат лимфу – прозрачную и практически бесцветную жидкость .
Особенности лимфы
Количество лимфы в организме человека составляет около 2 л. В ней практически отсутствуют эритроциты , содержится гораздо меньше белков по сравнению с плазмой крови . Но она содержит много лимфоцитов .
Лимфоциты – разновидность лейкоцитов, имеющих вид шарика, на поверхности которого находится много ворсинок, похожих на щупальца . С их помощью лимфоцит изучает поверхность других клеток и отыскивает чужеродные соединения – антигены . Именно лимфоциты обеспечивают защиту организма от бактерий и вирусов.
После того как человек поел жирной пищи, лимфа меняет свой цвет на молочно-белый. Это связано с тем, что в неё из кишечника всасывается значительная часть жира.
Лимфатическая система состоит из лимфатических капилляров , лимфатических сосудов и узлов .
Из плазмы крови образуется тканевая жидкость , которая омывает все клетки и ткани, отдавая им питательные вещества и кислород . Затем часть тканевой жидкости всасывается в лимфатические капилляры и образует лимфу.
Лимфатические капилляры начинаются слепо, иногда приобретая вид булавовидных расширений. Их стенки образованы только одним непрерывным слоем эпителиальных клеток, поэтому тканевая жидкость легко проникает внутрь них.
Лимфатические капилляры присутствуют во всех органах и тканях тела, кроме головного и спинного мозга, хрящей и костного мозга . Они имеют больший диаметр, чем кровеносные капилляры, – до 0,2 миллиметра. Лимфатические капилляры соединяются между собой и образуют лимфатические сети .
Из капилляров лимфа поступает в более крупные лимфатические сосуды . Движение лимфы происходит снизу вверх, от кончиков пальцев рук и ног. Поэтому на внутренних стенках лимфатических сосудов располагаются клапаны, которые препятствуют обратному оттоку лимфы . Благодаря клапанам кровь движется в одном направлении. Лимфатические сосуды заканчиваются у человека правым лимфатическим и грудным протоками .
Оба протока изливают лимфу в верхнюю полую вену большого круга кровообращения недалеко от сердца. В сутки в кровь возвращается от 1 до 3 литров лимфы.
По ходу лимфатических сосудов располагаются специальные образования – лимфатические узлы . Некоторые из них в виде округлых уплотнений можно найти под нижней челюстью. Их много также в подмышечной и подколенной впадинах, в паху и среди внутренних органов. У человека насчитывается более 460 лимфатических узлов. Снаружи они покрыты капсулами, от которых внутрь узла отходят перегородки. Между перегородками находятся скопления лимфоцитов, которые обезвреживают микроорганизмы . В лимфатических узлах происходит созревание лимфоцитов.
Здесь лимфатические сосуды распадаются на многочисленные узкие протоки, в которых происходит очистка лимфы , отфильтровываются погибшие клетки и бактерии. Таким образом, лимфатические узлы играютроль фильтров. Они входят в иммунную систему человека, потому что в них формируются лимфоциты.
Если в лимфатических узлах задерживается много бактерий, они увеличиваются в размерах, воспаляются и становятся болезненными.
Причиной воспаления лимфоузлов могут быть инфекционные и бактериальные заболевания.
Движение лимфы по сосудам. Ток лимфы происходит благодаря сокращениям мышечной стенки лимфатических сосудов, сдавливанию лимфатических сосудов сокращающимися мышцами и пульсации кровеносных сосудов. Лимфа движется по сосудам медленно, так как в лимфатической системе нет насоса, аналогичного сердцу.
Лимфатическая система. Она обеспечивает связь между органами и тканями , переносит многие вещества, которые всасываются в органах пищеварения, например жиры. Лимфатическая система дополняет работу кровеносной системы и осуществляет возвращение белков, жиров, воды и минеральных веществ из тканевой жидкости в кровь. Обеспечивает отток жидкости от органов. Находящиеся в лимфе лимфоциты выполняют защитную функцию, обеспечивая постоянство внутренней среды организма.
Итог урока.Лимфатическая система начинается слепо замкнутыми лимфатическими капиллярами, в которые попадает тканевая жидкость и образует лимфу. Далее из капилляров лимфа попадает в лимфатические сосуды, по ходу которых располагаются лимфатические узлы. В них происходит очищение лимфы.
По свойствам
Каковы же свойства крови в организме человека? Работа кровеносной системы зависит от функционирования сердечно-сосудистой системы. Кровь циркулирует под давлением и если учащенное сердцебиение, то она течет быстрее. Причем, движение крови замедляется или убыстряется в зависимости от сосудов, по которым она протекает.
В отличие от кроветворной системы лимфатическая не замкнута. Ее жидкость свободно поступает в органы и ткани. Циркуляция лимфы осуществляется посредством работы клапанов и сокращения сосудистых стенок. Но, в отличие от крови, лимфа течет намного медленнее, и повлиять на ее скорость нельзя.
Механизм движения лимфы
Лимфатическая система
Лимфатическая система собирает и выводит избыток жидкости, которая поступила из крови в ткани.
Еще в ней есть клетки, которые борются с инфекциями, не давая распространиться по всему телу патогенам — микробам, вызывающим болезни.
Все ткани организма омывает водянистая жидкость, которая просачивается из кровеносных сосудов. В основном она возвращается в вены, но часть превращается в другую жидкость — прозрачную лимфу. Она течет по сети лимфатических сосудов и поступает обратно в кровоток. Лимфа проходит через лимфатические узлы: в них есть клетки, которые борются с попавшими в лимфу микробами.
Болезни кровеносной системы человека
Кровообращение нуждается в сохранении полной замкнутости сосудистого русла, наполнения его кровью в допустимых пределах, нормальной проходимости и иннервации.
Врожденные аномалии расположения устьев легочных вен (в норме – все 4 находятся в левом предсердии)
Нарушение хотя бы одного из перечисленных выше условий отзывается местным расстройством кровообращения, которое может стать пуском для развития других заболеваний, или же само по себе представлять угрозу жизни. Заболевания могут быть наследственными или врожденными дефектами, и/или развиваться в течение жизни.
Кровеносная система: таблица частых патологий:
| Локализация | Название болезни |
| Сердце | Ишемическая болезнь сердца, коронарная недостаточность, инфаркт, аневризма аорты, обструктивные стенозы коронарных сосудов, коарктация аорты. |
| Головной мозг | Преходящее нарушение мозгового кровообращения, инсульт, инфаркт, дисциркуляторная энцефалопатия, болезнь «моямоя», цереброваскулярные патологии. |
| Артерии | Атеросклероз, атеросклероз Менкеберга, ангиопатия, аневризма, васкулит, расслоение, стеноз, облитерирующий эндартериит, эмболия. |
| Капилляры | Газовая эмболия, ретикулярная асфиксия (затрагивает кровеносные сосуды на лице), системный капиллярит, васкулит, склероз. |
| Вены | Ангиопатия, ретикулярный варикоз (на фото внизу), варикозные – застой, отек, расширение; язва сосуда, флебит, васкулит, эмболия. |
Самые распространенные патологии, в которых повинны и кровь, и кровеносная система – это тромбофлебит и тромбоз глубоких вен нижних конечностей.
Большинство перечисленных заболеваний относятся к необратимым, и лишь некоторые из них можно лечить с помощью хирургического вмешательства.
Случаи, когда для уточнения диагноза УЗИ кровеносных сосудов нижних конечностей не нужно
Сегодня заболевание № 1 – это артериальная гипертензия. Самыми распространенными причинами от которых страдают кровеносные сосуды и сердце, и при этом повышается артериальное давление, являются: неправильное питание, приводящее к атеросклерозу, а также малоподвижный образ жизни и курение.
Эти факторы еще больше снижают сосудистую эластичность, растягивают клапаны в венах и усугубляют нарушение функции кровеносных сосудов.
Схема стадий формирования атск-бляшки и УЗИ кровеносных сосудов с атеросклерозом
Как улучшить эластичность кровеносных сосудов?
Следует бороться с причинами:
- сбросить лишний вес и нормализовать питание – сократить жиры, включить в рацион продукты богатые витаминами (Р, А, Е) и минералами (кремний, селен, калий);
- пить побольше чистой воды – 30 мл на 1 кг массы тела;
- отказаться от курения;
- заниматься лечебной физкультурой – гимнастикой, развивающей гибкость, и кардионагрузками (ходьба со скандинавскими палками, плавание, аквааэробика);
- принимать контрастный душ, ежедневно, утром и вечером.
Какие принимать лекарства, лучше спросить у врача, так как все очень индивидуально, и те лекарственные препараты, которые будут полезны одним, могут быть категорически противопоказаны другим. Это же касается и народных средств, которые «обещают» сделать сосуды эластичными уже через пару недель, что в принципе невозможно.
Вышеперечисленный комплекс мероприятий поможет остановить прогрессирование старых и формирование новых атеросклеротических изменений, а регулярные занятия лечебной физкультурой позволят поддерживать в норме венозный отток.
https://youtube.com/watch?v=oUJSBm_9dnk
Заключительное видео в этой статье посвящено теме Васкулит или воспаление кровеносных сосудов. Про симптомы этой болезни, как себя вести при их появлении и каковы способы ее лечения рассказывается в передаче про медицину – «Жить здорово».




























